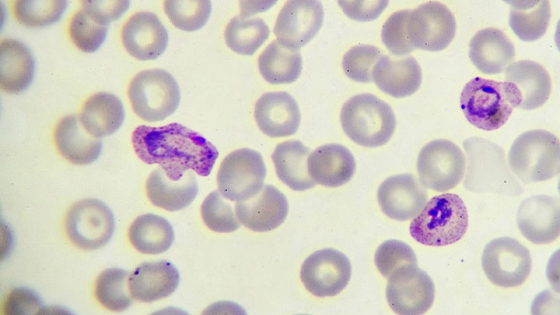
plasmodium parasite under a microscope

Core Facilities
Biophysics Core Facility
The Biophysics Core Facility supports Johns Hopkins Malaria Research Institute (JHMRI) investigators who want to characterize macromolecules or macromolecular complexes using biophysical techniques (isothermal titration calorimetry, dynamic light scattering, circular dichroism and x-ray crystallography).


Insectary Core Facility
This facility is dedicated to the production of mosquitoes for research purposes. The two major species reared are Anopheles gambiae and Anopheles stephensi. Aedes and Culex mosquitoes are also kept in the facility. Other mosquito species may be reared on demand. Research programs supported by the Insectary Core range from studies to understand the basic biology and physiology of arthropods to assessment of the interactions of pathogens with their arthropod vectors to the creation of transgenic mosquitoes. The projects are led by Johns Hopkins Malaria Research Institute (JHMRI) faculty investigating malaria, dengue and Lyme disease.
Parasitology Core Facility
The Parasitology Core Facility supports a variety of projects that focus on the parasite’s interactions with the mosquito vector and human host, and other biological processes that are associated with its capacity to transmit and infect. The facility comprises a state-of-the-art tissue culture room with relevant equipment. The Parasitology Core Facility provides Plasmodium falciparum asexual blood- and gametocyte-stage cultures, and both human and rodent Plasmodium sporozoite stages to meet the needs of JHMRI-affiliated groups. Specialized services are also provided upon request.

Johns Hopkins Malaria Research Institute at Macha, Zambia
The Malaria Institute at Macha (MIAM) is a malaria research field station and training center established through a collaborative Memorandum of Understanding between four partners—the Johns Hopkins Bloomberg School of Public Health and its Malaria Research Institute, the Zambian government, the Macha Mission Hospital and the Macha Malaria Research Institute. MIAM comprises infrastructure for field- and lab-based research, and facilities to host visiting scientists and students.
Genomic Analysis and Sequencing Facility
The Genomic Analysis and Sequencing Service Center provides expertise and service with: global expression analyses using microarray (Affymetrix GeneChip System and spotted array platforms) and deep sequencing; quantitative real time RT PCR for expression and SNP-based genotyping; processing and quality control of nucleic acid samples. The core also provides access to and training for multiple software packages for the analysis of expression and genotyping data. The core coordinates with technical support for customized assistance and adaptation to specific project needs.

Spatial Science Core
The Spatial Science Core provides the computing and statistical infrastructure and analysis expertise to interface satellite imaging, GPS information and epidemiological data to define relationships between environmental conditions and the transmission dynamics of infectious diseases including malaria.
BD Immunology and Flow Cytometry Laboratory
The Flow Cytometry and Cell Sorting Core Facility includes 2 flow cytometers: Becton Dickinson FACS Canto II (3 laser, 8 color) and a DakoCytomation MoFlo (3 laser, 6 color) for cell sorting (E1303A). The MoFlo is housed in BSL3. The Becton Dickinson Immune Function Laboratory is co-located with the core and includes a BD FACSCalibur (2 laser, 4 color), BD LSRII (3 laser, 14 color) (E1205) and BD FACSAria (3 laser, 9 color) for cell sorting (E1303B in BSL3), a CTL Immunospot reader (for ELISPOT analysis), MSD SECTOR Imager 2400 (for signal detection in MSD-based cytokine assays) and Carl Zeiss Axio Imager.D1 Digital Imaging Microscope. There is an offline Analysis Station with several flow cytometry analysis software programs.

